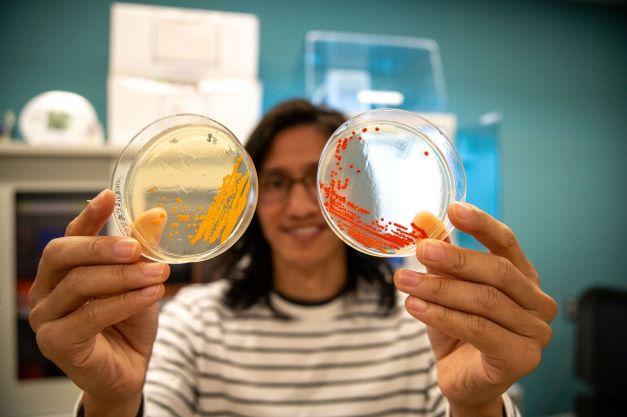
沖縄科学技術大学院大学キャンパスイメージ

最終更新日 :2021/07/30

おきなわかがくぎじゅつだいがくいんだいがく
沖縄科学技術大学院大学 /Okinawa Institute of Science and Technology Graduate University
沖縄県
私立
沖縄科学技術大学院大学(OIST)は科学分野の5年一貫制博士課程を置く学際的な大学院大学です。
OISTは、国内外から優れた研究者を集めて質の高い研究を行い、世界レベルの研究拠点の形成を推進し、沖縄における技術移転およびイノベーションを促進する知的クラスターの核となることを通して、世界の科学技術へ寄与するために日本政府の主導により創設されました。
基本情報
- 奨学金制度
- 無
- 特記事項
- 後日公開予定
- 授業料減免制度
- 無
- (特記事項)
- 後日公開予定
- 住居支援
-
学生寮の提供 : 有(留学生全員対象) 学生寮の提供以外の支援 : 有(留学生全員対象) - お祈り専用の部屋有無
- 有
- 学食等で宗教に配慮した食事の提供がされている
- 有